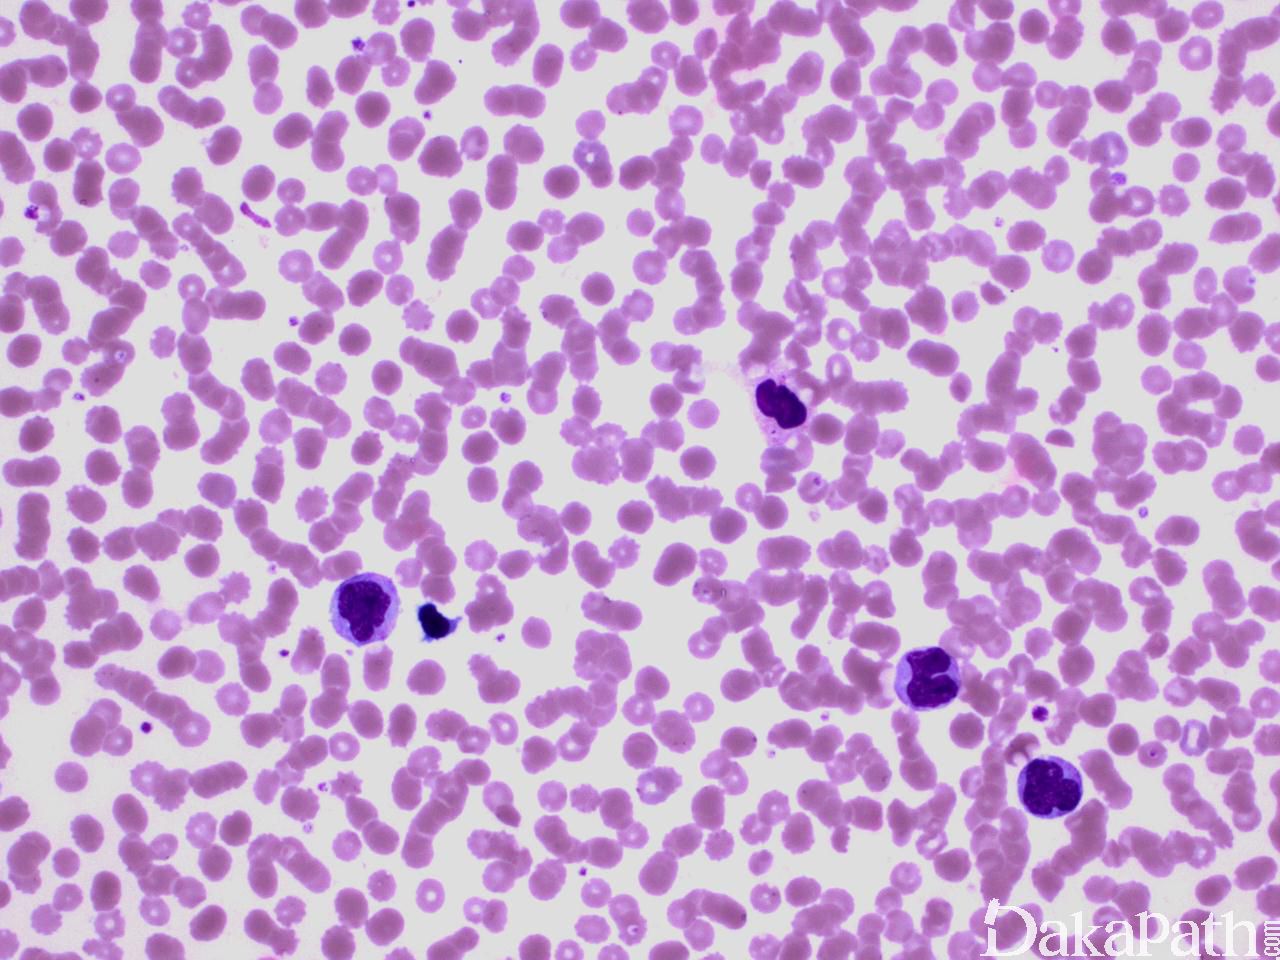
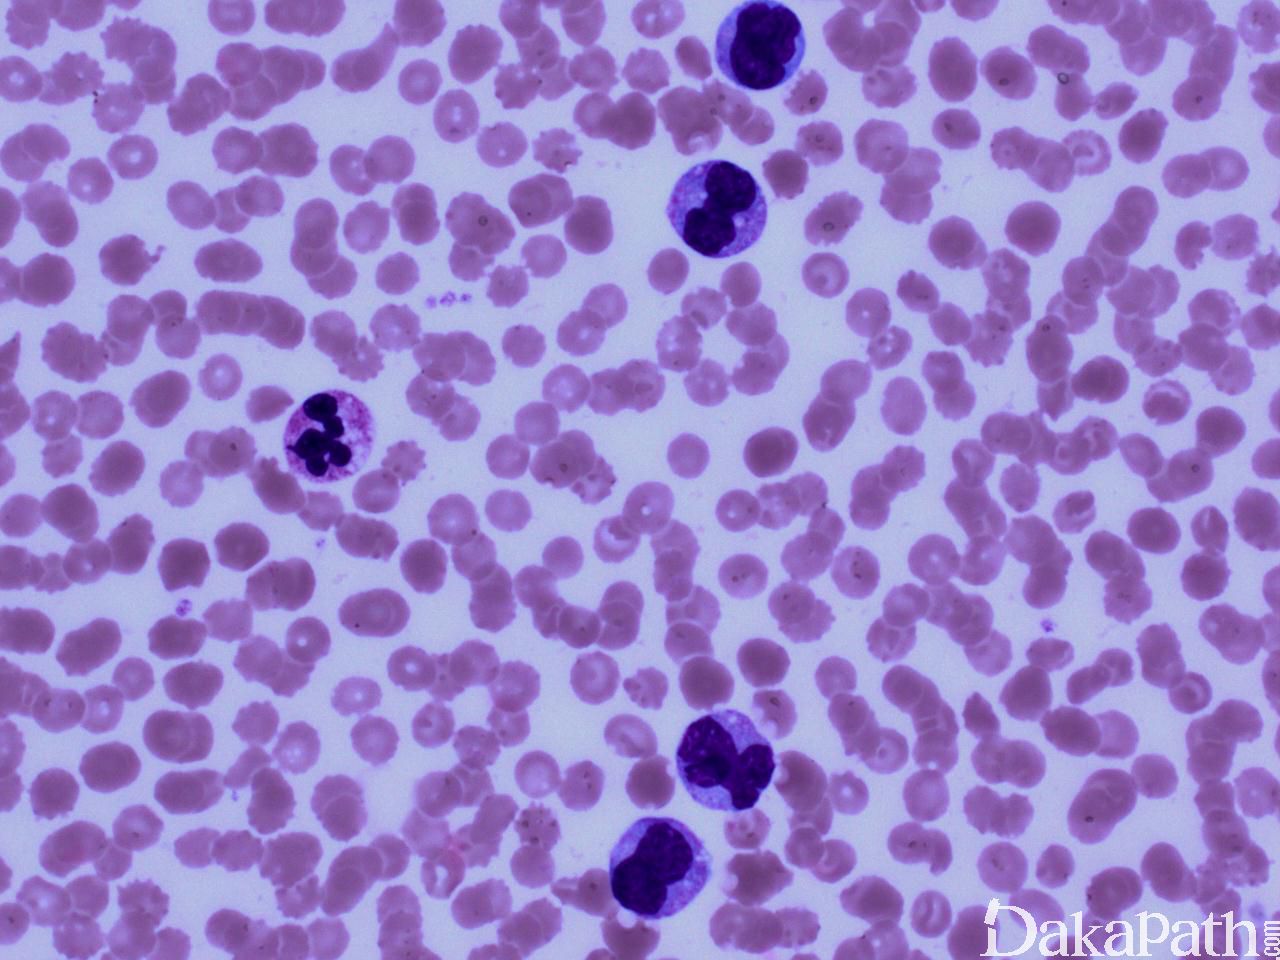
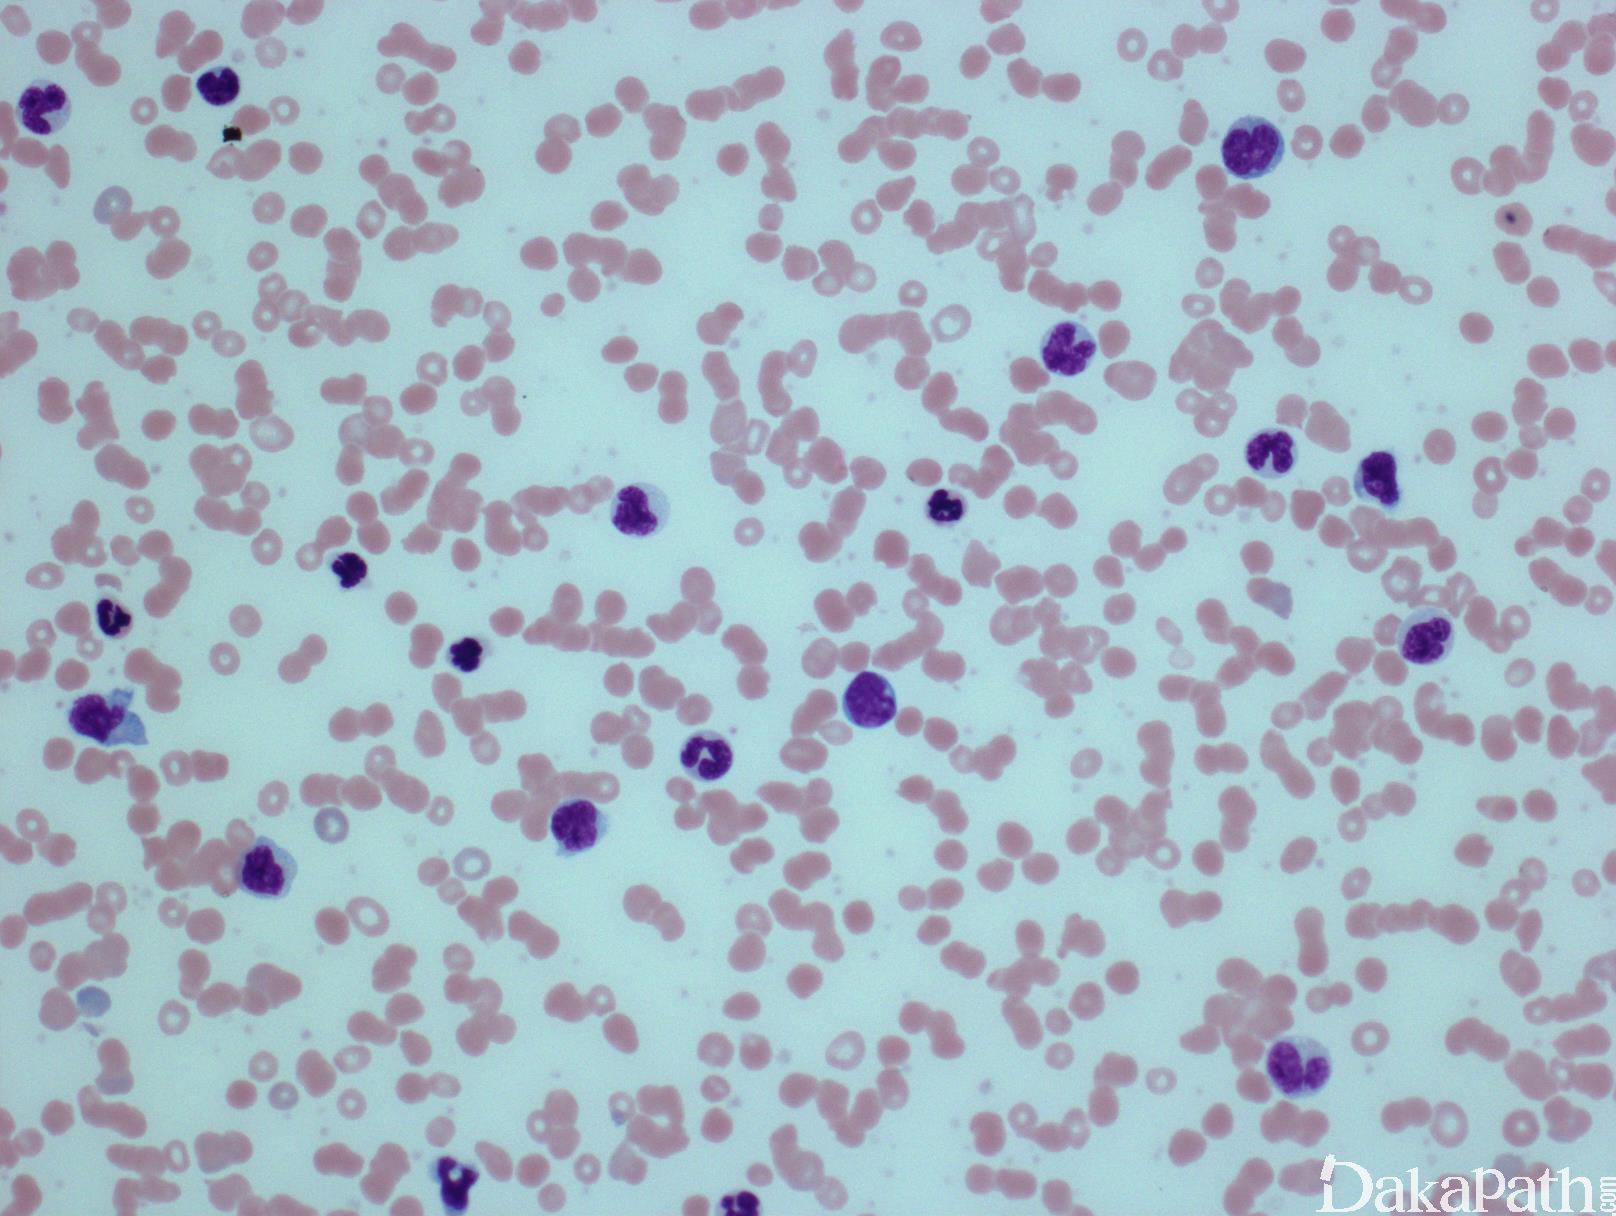
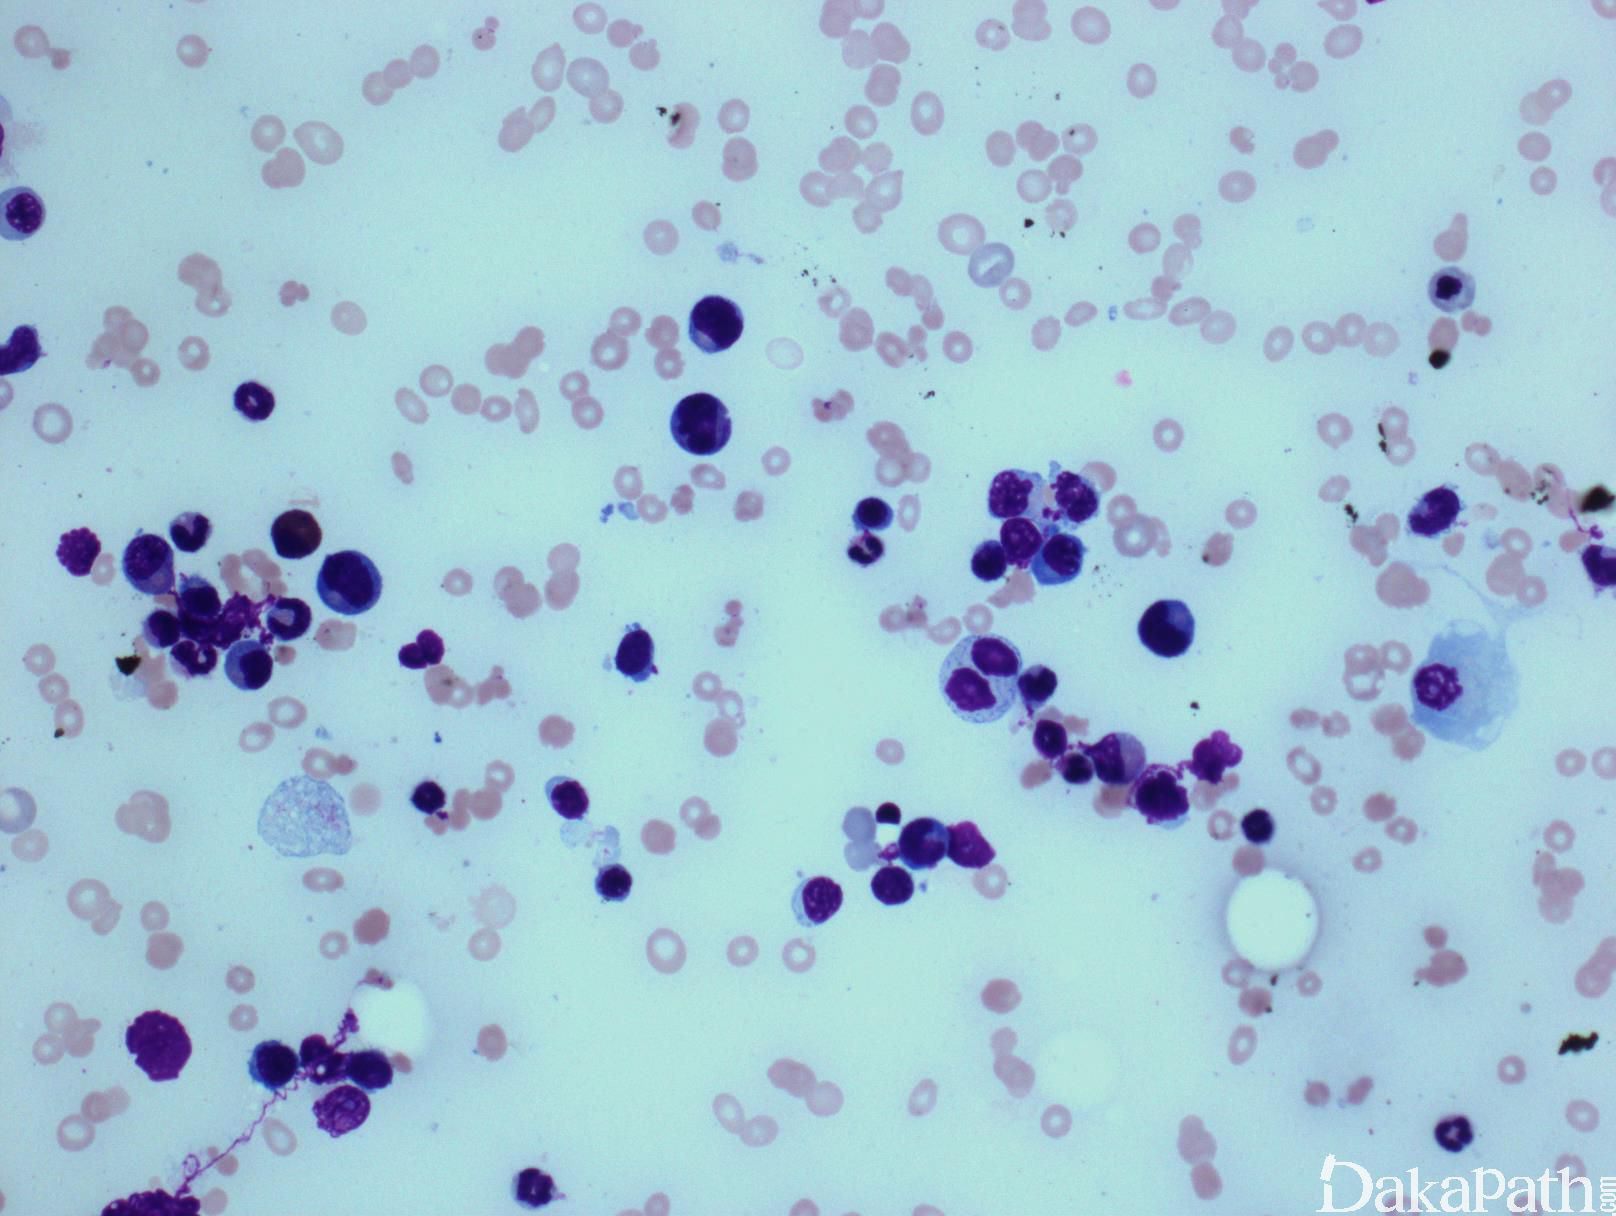

慢性粒-单核细胞白血病
Chronic Myelomonocytic Leukemia (CMML)
概述:
慢性粒-单核细胞性白血病为克隆性造血细胞恶性肿瘤,同时具有骨髓增生性肿瘤与骨髓增生异常综合征的特点, 尤其是外周血持续性单核细胞增多。根据外周血和骨髓中母细胞/幼单核细胞多少,分为三种类型:CMML0,CMML1 和 CMML2。
诊断要点:
临床表现及形态学
成人总体年发病率约为 0.4/100000,中位诊断年龄 65-75 岁,男性较女性多见(1.5-3:1)。超过 50%患者白细胞增高,其余白细胞计数正常或由于中性粒细胞减少而白细胞减少。按白细胞计数可将 CMML 分为骨髓增殖型(白细胞数 ≥13×109/L)和骨髓增生异常型(白细胞数<13×109/L)。前者临床多表现为体重减轻、发热、盗汗,而后者表现常与造血功能不足有关如乏力、感染和血小板低下引起的出血。二者都可出现肝、脾肿大,尽管更较常见于白细胞增高病例,其也更可能有淋巴结增大和白血病性皮肤浸润。
CMML 的标志性特征是外周血单核细胞增高。根据定义,外周血单核细胞计数总是 ≥1×109/L,通常 2-5×109/L,但可以高达 80×109/L,且单核细胞要占白细胞的 10%以上。CMML 外周血中单核细胞为的成熟型,无明显形态学异常;但可出现胞浆颗粒和核分叶异常及纤细的核染色质,具有这类特征细胞最好称为异常单核细胞,用于描述有一定形态学异常和轻微不成熟而又缺乏幼单核细胞特点的单核细胞。幼单核细胞在 CMML 中被认为等同于原始细胞,细胞较不成熟,核染色质细腻、核仁小而不明显,胞质含细颗粒。原始细胞包括原粒细胞和原单核细胞。原单核细胞体积大,胞质丰富,弱噬碱,可含有细颗粒,一个或多个突出核仁。原粒细胞、原单核细胞和幼单核细胞与更为成熟的异常单核细胞和正常单核细胞的区分,对于 CMML 和 AML 的鉴别诊断非常重要。如果原始细胞(原粒细胞、原单核细胞和幼单核细胞)占白细胞总数 20%或以上,则应诊断为 AML。中性粒细胞计数可以增高、正常或减低,前体粒细胞(早幼粒、中幼粒、晚幼粒)应<10%。粒细胞有不同程度的异形性(如少颗粒、低分叶)。可有轻度噬碱细胞增高,噬酸粒细胞一般正常或轻度增多,但偶而显著增高,此时可诊断为 CMML 伴噬酸细胞增高,但髓/淋系肿瘤伴噬酸细胞增高和特异遗传学异常(如 PDGFRB)必须除外。常有轻度贫血,血小板计数不等,可中度减少并形态异常。多数病例骨髓细胞密度增高,但也可以正常,减低罕见。最突出表现是粒系增殖,也总是有单核增生(程度不等),但骨髓涂片形态学不容易辨认。细胞化学或免疫组化染色有助识别单核及其前体细胞。如同外周血,粒系有不同呈度异形性,红系也有轻度异形性,80%病例有巨核细胞异形如微巨核细胞或少分叶巨核细胞。2017 年版 WHO 根据外周血和骨髓中原始细胞(原粒细胞、原单核细胞、幼单核细胞)比例,将 CMML 分为 3 种类型:CMML0,原始细胞外周血中 <2%和骨髓中 <5%,无 Auer 小体;CMML1,原始细胞外周血中 2-4% (< 5%),骨髓中 5-9% (<10%),无 Auer 小体;CMML2,原始细胞外周血中 5-19% (<20%),骨髓中 10-19% (<20%) ,或有 Auer 小体。
诊断标准(2017 年版 WHO ):
外周血持续单核细胞增多 ≥1×109/L(并占白细胞比例>10%);
不满足 WHO BCR-ABL1 阳性 CML、真性红细胞增多症、原发性骨髓纤维化、原发性血小板增多症 a 的诊断标准;
无 PDGFRA、PDGFRB、FGFR1 重排,无 PCM1-JAK2. 融合(特别是伴有噬酸细胞增多的病例);
外周血及骨髓中母细胞 b<20%;
髓系中至少有一系呈现形态异型
或
如骨髓增生异常轻微或缺如, 但满足上述其它 4 条
- - 且骨髓细胞有获得性克隆性细胞或分子遗传学异常 c,
或
- - 单核细胞持续增多至少 3 个月并能排除所有引起单核细胞增多的其他原因(如恶性肿瘤、感染、炎症)。
a 骨髓增生性肿瘤(MPN)可以有单核细胞增多或在其病程中出现单核细胞增多,表现与 CMML 相似。根据这些病例的病史记录可除外 CMML。骨髓中呈现 MPN 特征或存在 MPN 相关的突变(JAK 2、CALR 或 MPL)倾向于支持 MPN 伴单核细胞增高而不是 CMML。
b 原始细胞和其等同细胞包括原始粒细胞、原始单核细胞和幼单核细胞。幼单核细胞系单核细胞前体,具有丰富的淡灰色或微噬碱胞质、散在细颗粒、精细分布点状染色质,等度不等的突出核仁和纤细的核折叠。外周血和骨髓中的异常单核细胞不能计作原始细胞。
c 如临床符合的话,存在常与 CMML 相关的基因突变(如 TET2. SRSF2. ASXL1 和 SETBP1)支持 CMML 的诊断,但有些突变与年龄相关或者存在于其它肿瘤,因此,必须谨慎解释这些突变的意义。
免疫表型
流式细胞学白血病细胞表达粒一单核细胞标记,如 CD33 和 CD13;不同程度地表达 CD14. CD68 和 CD64,并可有多个抗原的异常表达,如 CD56. CD2 或低表达 HLA-DR、CD14. CD13. CD36. CD15 或 CD64。一些表型异常,如低表达 CD14,可能反映单核细胞的不成熟。成熟中的中性粒细胞也可出现异常表型特点,如成熟相关抗原表达的不同步。CD34+细胞数增多或出现异常免疫表型的原始细胞群预示可能发生 AML 转化。骨髓活检组织切片免疫组化可与骨髓细胞组织结构联系起来评估细胞成分,溶菌酶与 CAE 细胞化学染色联合应用便于识别单核细胞,单核细胞为溶菌酶阳性、CAE 阴性,而粒细胞二者均阳性。 CD34 组化阳性细胞增高与急性白血病转化相关。
遗传学
CMML 无特定的细胞遗传学异常。异常核型仅见于 20%~ 40%病例,最常见的重现性异常包括+8. -7. -5. del(7q) 以及复杂核型。11q23 异常在 CMML 中不常见。若存在,应小心排除 AML 的可能。
预后
CMML 生存期从 1 个月到 100 个月(多数病例中位生存时间 20-40 个月)。15-30%病例转化为急性白血病,一般属于急性髓系白血病伴异形增生相关改变,其原始细胞形态具有急性粒-单细胞白血病或急性单核细胞白血病的特征。

鉴别诊断:
- 反应性单核细胞增多 : 感染、自身免疫病等可导致发应性外周血单核细胞增高,一般没有异型,原始细胞不高。临床病史有助鉴别。
- 急性髓-单核细胞白血病(AMML) :主要是与 CMML2 相鉴别,这很大程度上依赖于对高质量骨髓标本的形态学分析,即原始粒细胞,原始单核细胞和幼单核细胞的计数(幼单核细胞等同于原始细胞),其总和达 20%者为 AMML。
- 慢性粒细胞白血病 ,BCR-ABL+:主要表现为中性粒细胞显著增生,单核细胞通常比例不高,但少数病例(P190)单核细胞可明显增高。其它形态学特征有助鉴别,如细胞无或仅轻微异型,噬碱粒细胞明显增多,骨髓见特征性的少叶、小型或“侏儒”巨核细胞。遗传学有 Ph 染色体或 BCR-ABL1 融合基因。
- 不典型慢性粒细胞白血病,BCR-ABL-: 主要是中性粒细胞增生伴显著异型,不成熟中性粒细胞>10%,单核细胞比例不高(<10%)。
- 髓系肿瘤伴 PDGFRB 重排: 形态学可类似 CMML,但同时伴有噬酸性粒细胞增高,染色体检查有助诊断。
- 骨髓异型增生性肿瘤 :细胞异型性可与 CMML 相似,但单核细胞不高或增生不明显(<1×109/L)。
